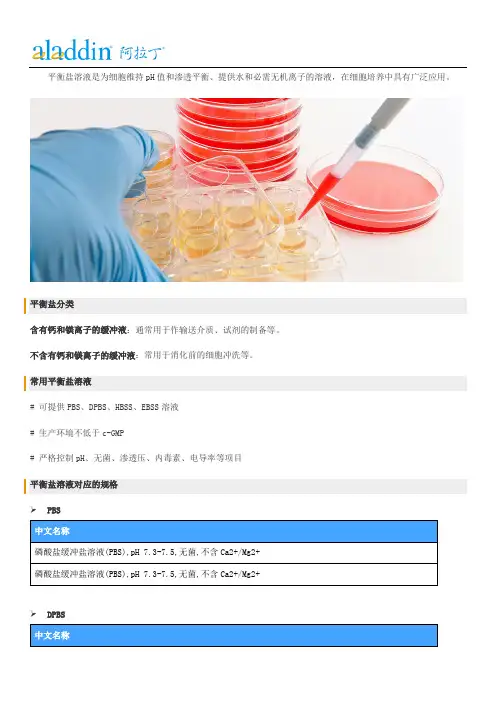

Earle's平衡盐溶液(10×EBSS,含钙镁糖)
- 格式:doc
- 大小:37.00 KB
- 文档页数:1

磷酸缓冲盐溶液(10×PBS,无钙镁)产品简介:平衡盐溶液(Balanced Salt Solution,BSS)与细胞生长状态下的pH值、渗透压等环境状态一致,具有维持渗透压、控制酸碱平衡、供给细胞生存代谢所必需的能量和无机盐成分等作用,可满足体外实验中,细胞生存并维持一定的代谢的基本需要。
平衡盐溶液(BSS)主要由无机离子组成,有时含有碳酸氢钠、葡萄糖、酚红等,如果有必要还可以加入HEPES,加入少量的HEPES后,可以减少氯化钠的加入量,以维持渗透压的平衡。
平衡盐溶液可以作为完全培养基的基液,亦可以用于稀释浓缩的氨基酸、维生素溶液以配制完全培养基。
BBS配方常有改动,如Hank’s BBS由不含钙镁或酚红的,也有含钙镁含酚红的等等, Dulbecco’s PBS由不含钙镁或含钙镁的等。
HBSS、EBSS、PBS等都是与较弱的磷酸盐缓冲液相关的盐溶液。
常见的平衡盐溶液有Eargle液,Hanks’液、低钙镁和无钙、镁平衡盐溶液及磷酸盐缓冲液 (PBS)等。
磷酸缓冲盐溶液(10×PBS,无钙镁)即Phosphate-Buffered Saline,是最常用的磷酸盐缓冲溶液,又称Dulbecco’s磷酸缓冲盐溶液、Dulbecco’s PBS、D-PBSA、CMF-DPBS 或D-PBS、DPBS溶液, 主要由氯化钠、氯化钾、磷酸氢二钠、磷酸二氢钾组成,不含钙离子和镁离子,pH值为7.4,该试剂经过高压灭菌,常用于细胞培养过程中细胞的洗涤或其他常规用途。
该试剂为10×浓缩液,使用之前应稀释到1×。
主要成分:主要由NaCl、KCl、Na2HPO4、KH2PO4等组成。
操作步骤(仅供参考):1、进行细胞培养过程中细胞的洗涤时,按10×PBS:无菌水=1:9进行稀释,即取10×PBS 1份、无菌水9份,充分混匀,即获得PBS工作液。
2、进行常规实验(不要求无菌)时,按10×PBS:双蒸水或去离子水=1:9进行稀释,即取10×PBS 1份、双蒸水或去离子水9份,充分混匀,即获得PBS工作液。

earle’s平衡盐标准一、背景介绍平衡盐是人体内一种重要的电解质,对于维持人体生命和健康至关重要。
近年来,随着人们健康意识的提高,平衡盐的摄入量也逐渐受到关注。
然而,市场上平衡盐的种类繁多,品质参差不齐。
因此,制定一个平衡盐的标准对于保证平衡盐的品质和安全性具有重要意义。
earle’s平衡盐是一种经过科学配方制成的平衡盐产品,其特点在于富含人体所需的多种矿物质和微量元素,同时保持低钠、低盐、低卡路里等特性,适合各类人群食用。
earle’s平衡盐的生产过程严格遵循国际卫生标准,确保产品的安全和品质。
1. 原料来源:earle’s平衡盐的原料必须来自无污染、无公害的优质土地,确保原料的天然、纯净。
2. 配方比例:earle’s平衡盐的配方必须科学合理,符合国际卫生标准,各种矿物质和微量元素的比例必须均衡。
3. 生产工艺:earle’s平衡盐的生产过程必须严格遵循国际卫生标准,确保产品的安全和品质。
生产过程中不得添加任何化学添加剂和防腐剂。
4. 包装标识:earle’s平衡盐的包装上必须明确标明产品名称、生产厂家、生产日期、保质期、营养成分表等信息,同时需要注明产品为平衡盐产品。
5. 检测认证:e arle’s平衡盐需要通过相关部门的检测和认证,确保产品的安全和品质。
制定earle’s平衡盐标准的意义在于规范平衡盐市场,提高平衡盐的品质和安全性,保障消费者的健康权益。
同时,通过标准的实施,可以促进平衡盐产业的健康发展,提高企业的竞争力和市场占有率。
五、实施earle’s平衡盐标准面临的挑战1. 执行难度:由于平衡盐市场的庞大和复杂,标准的执行可能会面临一定的难度和挑战,需要相关部门和企业的共同努力和支持。
2. 成本问题:实施标准需要一定的成本投入,包括检测费用、认证费用等,对于一些中小企业可能会带来一定的经济压力。
3. 市场竞争:实施标准可能会对一些不符合标准的企业产生影响,导致市场竞争格局的变化,需要企业做好应对措施。

《Earle's盐成分表》一、背景介绍Earle's盐是一种最早由Earle在1950年代设计的细胞培养基配方。
其成分的合理搭配,使之成为了一种被广泛应用于细胞培养实验中的培养基。
在细胞培养实验中,为了更好地控制和了解培养的细胞状态,科研人员需要对培养基的成分进行了解和分析。
Earle's盐成分表成为了必要的信息之一,可以帮助科研人员更好地了解该培养基的配方及其成分。
二、Earle's盐的基本组成Earle's盐是由多种化学物质组成的,不同的成分在培养细胞时扮演着不同的角色。
下面我们来具体了解Earle's盐的基本组成。
1. 离子成分Earle's盐主要包括氯化物、磷酸盐和碳酸氢根等离子成分。
这些离子是细胞正常生长和代谢所必须的,通过培养基提供这些离子,可以满足细胞在培养中生长和繁衍所需的基本元素。
2. 胺基酸Earle's盐中还包括多种氨基酸,如丝氨酸、赖氨酸等。
这些氨基酸是细胞合成蛋白质的基本原料,通过培养基中提供这些氨基酸,可以促进细胞对蛋白质的合成和代谢过程。
3. 维生素Earle's盐中还包括多种维生素成分,如维生素B12、叶酸等。
这些维生素在细胞的代谢过程中起着重要的作用,通过培养基中提供这些维生素,可以促进细胞的正常代谢和生长。
4. 糖类Earle's盐中还包括葡萄糖等糖类成分,这些糖类是细胞生长和能量代谢所必须的物质,在培养基中提供这些糖类,可以满足细胞对能量的需求。
5. 添加剂除了以上基本成分外,Earle's盐中还会添加一些辅助成分,如胰蛋白酶、牛血清等。
这些添加剂可以帮助细胞更好地在培养基中生长和繁殖。
三、Earle's盐成分表的作用Earle's盐成分表是对培养基中各种成分的详细描述和记录,它的作用主要有以下几个方面:1. 了解培养基的配方通过Earle's盐成分表,可以清晰地了解培养基中各种成分的配方和比例,这有助于科研人员更好地掌握培养基的原理和作用机制。

earle's平衡盐是一种非常重要的化学试剂,常用于细胞培养和生物实验中,是一种模拟真实细胞环境的培养基成分。
在科研和医药领域,尤其是细胞培养实验方面,其重要性不言而喻。
对于earle's平衡盐在实验室中的使用,FDA也有一定的标准和规定。
我们来看一下earle's平衡盐的成分和作用。
earle's平衡盐包含多种无机盐和氨基酸,能够提供细胞培养所需的营养物质和稳定的环境。
它能够维持细胞内外的渗透压平衡,保持细胞的正常形态和功能。
在细胞培养和生物实验中,使用earle's平衡盐可以更好地模拟体内环境,使实验结果更加真实可靠。
针对earle's平衡盐的使用,FDA也有一些规定和标准。
在细胞培养实验中,特别是在药物检测和生物制品研发中使用earle's平衡盐时,需要确保其符合FDA的标准。
这些标准主要包括对制备工艺、原料质量和产品质量的要求。
需要保证earle's平衡盐的配方合理,无机盐和氨基酸的含量和比例符合要求,且无重金属和微生物污染等不良物质。
在实际使用earle's平衡盐时,我们也需要注意一些使用上的注意事项。
要根据实验需要选择合适的类型和规格的earle's平衡盐,确保其质量和纯度符合要求。
在使用过程中需要严格按照规定的配制方法和浓度来使用,避免浓度过高或过低对细胞产生不良影响。
另外,还需要对使用后的废弃物进行正确的处理,避免对环境造成污染。
从个人的角度来看,我认为对earle's平衡盐的使用需要非常重视其质量和标准要求。
作为细胞培养和生物实验中的重要试剂,其质量直接关系到实验结果的可靠性和准确性。
在选择和使用earle's平衡盐时,应该严格遵循FDA的标准和规定,确保其质量达标,从而保证实验结果的可靠性。
earle's平衡盐作为细胞培养和生物实验中的重要试剂,其质量和标准至关重要。
我们需要充分了解其成分和作用,在使用时严格按照FDA 的标准来选择和配制,确保其质量符合要求。

生命科学细胞培养缓冲液配制北京华越洋生物磷酸缓冲盐粉剂(1×PBS,含钙镁) 1L 细胞培养45% 室温,24个月最常用的磷酸盐缓冲溶液,又称Dulbecco's磷酸缓冲盐溶液、D-PBSB、D-PBS溶液,含钙镁,常用于细胞培养过程中细胞的洗涤或其他常规用途。
"主要由137mM NaCl, 2.68mM KCl, 8.1mM Na2HPO4, 1.47mM KH2PO4,1.8mMCaCl2,3.98mM镁离子组成,该粉剂溶于水后pH值为7.2~7.4。
使用时,取粉末充分溶解于水即可使用,如要求无菌,应高压灭菌或过滤除菌。
磷酸缓冲盐粉剂(1×PBS,含钙镁) 10×1L 细胞培养45% 室温,24个月最常用的磷酸盐缓冲溶液,又称Dulbecco's磷酸缓冲盐溶液、D-PBSB、D-PBS溶液,含钙镁,常用于细胞培养过程中细胞的洗涤或其他常规用途。
"主要由137mM NaCl, 2.68mM KCl, 8.1mM Na2HPO4, 1.47mM KH2PO4,1.8mMCaCl2,3.98mM镁离子组成,该粉剂溶于水后pH值为7.2~7.4。
使用时,取粉末充分溶解于水即可使用,如要求无菌,应高压灭菌或过滤除菌。
磷酸缓冲盐粉剂(1×PBS,无钙镁) 1L 细胞培养45% 室温,24个月最常用的磷酸盐缓冲溶液,又称Dulbecco磷酸缓冲盐溶液、D-PBSA、CMF-DPBS溶液或DPBS溶液,不含钙离子和镁离子,常用于细胞培养过程中细胞的洗涤或其他常规用途主要由137mM NaCl, 2.68mM KCl, 8.1mM Na2HPO4,1.47mM KH2PO4组成,该粉剂溶于水后pH值为7.4。
现货磷酸缓冲盐粉剂(1×PBS,无钙镁) 2L 细胞培养45% 室温,24个月最常用的磷酸盐缓冲溶液,又称Dulbecco磷酸缓冲盐溶液、D-PBSA、CMF-DPBS溶液或DPBS溶液,不含钙离子和镁离子,常用于细胞培养过程中细胞的洗涤或其他常规用途主要由137mM NaCl, 2.68mM KCl, 8.1mM Na2HPO4,1.47mM KH2PO4组成,该粉剂溶于水后pH值为7.4。

细胞培养常见问题及其解决1. 如何选用特殊细胞系培养基?培养某一类型细胞没有固定的培养条件。
在MEM中培养的细胞,很可能在DMEM或M199中同样很容易生长。
总之,首选MEM做粘附细胞培养、RPMI-1640做悬浮细胞培养是一个好的开始。
2. 何时须更换培养基?视细胞生长密度而定,或遵照细胞株基本数据上之更换时间,按时更换培养基即可。
3. 可否使用与原先培养条件不同之培养基?不能。
每一细胞株均有其特定使用且已适应之细胞培养基,若骤然使用和原先提供之培养条件不同之培养基,细胞大都无法立即适应,造成细胞无法存活。
4 可否使用与原先培养条件不同之血清种类?不能。
血清是细胞培养上一个极为重要的营养来源,所以血清的种类和品质对于细胞的生长会产生极大的影响。
来自不同物种的血清,在一些物质或分子的量或内容物上都有所不同,血清使用错误常会造成细胞无法存活。
5 何谓FBS, FCS, CS, HS ?FBS (fetal bovine serum) 和FCS (fetal calf serum) 是相同的意思,两者都是指胎牛血清, FCS 乃错误的使用字眼,请不要再使用。
CS (calf serum) 则是指小牛血清。
HS (horseserum) 则是指马血清。
6 培养细胞时应使用5 % 或10% CO2?或根本没有影响?一般培养基中大都使用HCO3-/CO32-/H+ 作为pH 的缓冲系统,而培养基中NaHCO3 的含量将决定细胞培养时应使用的CO2 浓度。
当培养基中NaHCO3 含量为每公升3.7 g 时,细胞培养时应使用10 % CO2;当培养基中NaHCO3 为每公升1.5 g 时,则应使用5 % CO2 培养细胞。
7.Hank's 平衡盐溶液(HBS)要在空气中使用,不需要CO2培养箱。
原因是什么?Hank's 平衡盐溶液(HBS)和Earle's平衡盐溶液(EBS)有什么本质的功能差别?HBS和 EBS 的主要差别在于碳酸氢钠的水平,在Eagles (2.2g/L)中比在Hanks (0.35g/L) 中高。

MDC:取12 mg粉末溶于720 nl DMSO使其浓度为50 mmol/L,分装后-20冰箱保存。
临用前用MEM稀释到终浓度50 umol/L;Rapamycin:用MEM培养基配成终浓度为1 umol/L,现用现配;400ng/ml喹乙醇:称取4 mg喹乙醇,DMSO预溶(体积<0.1%)后加入10 ml MEM培养液至完全溶解,现用现配,避光保存;3-MA:首先用PBS溶解粉末,临用前加热至完全溶解后再加入MEM培养基至终浓度10mmol/L; PI3K抑制剂(3-MA,Wortmannin)可干扰或阻断自噬体的形成用RAPAMYCIN诱导自噬我也查过一部分文献,有用无血清的,也有用,一般培养基的,浓度从25nM到100nM都有,用的是50nM的雷帕霉素,加入一般的培养基中,目的是排除无血清所诱导出来的自噬。
文献说饥饿初期激活的是大分子自噬,在4-6小时活力达到最大,24h后以CMA途径为主Earle's balanced salts solution (EBSS) for 48 hsigma的EBSS,货号E2888,有碳酸氢钠,有酚红的,酚红到不是很必须,只是一个PH指示作用,好看些无血清诱导自噬:EBSS 诱导6个小时就可以了。
EBSS一定可以诱导出来,只是需要说明的是时间点的设置,因为从饥饿诱导开始半个小时就可能开始自噬了,一直到24小时都持续,所以应该设置不同的时间点观察这个作用。
另外一个很大的问题是,饥饿诱导的一个很大的弊端是细胞死亡,这也是我面临的问题,就是在细胞收养的时候蛋白浓度太小了。
24小时就很少了,更不要说48小时和72小时了Hank's诱导,也就是通常所说的饥饿诱导,细胞培养到对数生长期后以Hank's替代常规完全培养基,3h后就可诱导出自噬。
我用Hank's诱导了3h后电镜观察有30%细胞都有自噬这种现象,但不如国外报道的高。

北京雷根生物技术有限公司 Hanks 平衡盐溶液(5×HBSS,无酚红)简介:常见的平衡盐溶液有Eargle 's 液、Hank's 液、磷酸盐缓冲溶液(PBS)等。
Hanks 平衡盐溶液是最常用的磷酸盐缓冲溶液之一,又称Hanks' Balanced Salt Solution 、Hanks' BSS 、HBSS, 主要由氯化钠、氯化钾、磷酸盐、碳酸氢钠、葡萄糖等组成,含Ca 2+、Mg 2+、酚红,pH 值一般为7.2~7.4。
Leagene Hanks 平衡盐溶液(5×,无酚红),含Ca 2+、Mg 2+,不含酚红,用重蒸超纯水配制,pH 值7.4,经严格过滤除菌处理,内毒素含量低,可用于胰蛋白酶-EDT A 细胞消化液等各种无或低钙镁细胞培养用液的配制以及组织和细胞的漂洗等。
组成:操作步骤(仅供参考):1、 进行细胞培养过程中细胞的洗涤时,按5×HBSS 溶液:无菌水=1:4进行稀释,即取5×HBSS 溶液1份、无菌水4份,充分混匀,即获得HBSS 工作液。
2、 进行常规实验(不要求无菌)时,按5×HBSS 溶液:双蒸水或去离子水=1:4进行稀释,即取5×HBSS 溶液1份、双蒸水或去离子水4份,充分混匀,即获得HBSS 工作液。
3、 取HBSS 工作液进行下游实验。
注意事项:1、 在进行细胞培养过程中细胞的洗涤时,应注意无菌操作,避免被微生物污染。
2、 Leagene Hanks 平衡盐溶液(5×HBSS,无酚红)由于含钙离子,尤其其他盐离子浓度也很高,易产生少许沉淀,出现该种情况后,一般置于温浴至沉淀溶解即可,如果产生的沉淀较多应弃用。
3、 该试剂经过滤除菌。
4、 为了您的安全和健康,请穿实验服并戴一次性手套操作。
编号 名称 CC0035 Storage Hanks 平衡盐溶液(5×HBSS,无酚红) 500ml 4℃ 使用说明书 1份。

细胞培养常见问题及其解决1、如何选用特殊细胞系培养基?培养某一类型细胞没有固定的培养条件。
在MEM中培养的细胞,很可能在DMEM或M199中同样很容易生长。
总之,首选MEM做粘附细胞培养、RPMI-1640做悬浮细胞培养是一个好的开始。
2、何时须更换培养基?视细胞生长密度而定,或遵照细胞株基本数据上之更换时间,按时更换培养基即可。
3、可否使用与原先培养条件不同之培养基?不能。
每一细胞株均有其特定使用且已适应之细胞培养基,若骤然使用和原先提供之培养条件不同之培养基,细胞大都无法立即适应,造成细胞无法存活。
4、可否使用与原先培养条件不同之血清种类?不能。
血清是细胞培养上一个极为重要的营养来源,所以血清的种类和品质对于细胞的生长会产生极大的影响。
来自不同物种的血清,在一些物质或分子的量或内容物上都有所不同,血清使用错误常会造成细胞无法存活。
5、何谓FBS, FCS, CS, HS ?FBS (fetal bovine serum) 和FCS (fetal calf serum) 是相同的意思,两者都是指胎牛血清, FCS 乃错误的使用字眼,请不要再使用。
CS (calf serum) 则是指小牛血清。
HS (horseserum) 则是指马血清。
6、培养细胞时应使用5 % 或10% CO2?或根本没有影响?一般培养基中大都使用HCO3-/CO32-/H+ 作为pH 的缓冲系统,而培养基中NaHCO3 的含量将决定细胞培养时应使用的CO2 浓度。
当培养基中NaHCO3 含量为每公升3.7 g 时,细胞培养时应使用10 % CO2;当培养基中NaHCO3 为每公升1.5 g 时,则应使用5 % CO2 培养细胞。
7、Hank's 平衡盐溶液(HBS)要在空气中使用,不需要CO2培养箱。
原因是什么?Hank's 平衡盐溶液(HBS)和Earle's平衡盐溶液(EBS)有什么本质的功能差别?HBS和 EBS 的主要差别在于碳酸氢钠的水平,在Eagles (2.2g/L)中比在Hanks (0.35g/L) 中高。

D-Hanks平衡盐溶液(1×,含酚红)产品简介:平衡盐溶液(Balanced Salt Solution,BSS)与细胞生长状态下的pH值、渗透压等环境状态一致,具有维持渗透压、控制酸碱平衡、供给细胞生存代谢所必需的能量和无机盐成分等作用,可满足体外实验中,细胞生存并维持一定的代谢的基本需要。
平衡盐溶液(BSS)主要由无机离子组成,有时含有碳酸氢钠、葡萄糖、酚红等,如果有必要还可以加入HEPES,加入少量的HEPES后,可以减少氯化钠的加入量,以维持渗透压的平衡。
平衡盐溶液可以作为完全培养基的基液,亦可以用于稀释浓缩的氨基酸、维生素溶液以配制完全培养基。
BBS配方常有改动,如Hank’s BBS由不含钙镁或酚红的,也有含钙镁含酚红的等等, Dulbecco’s PBS由不含钙镁或含钙镁的等。
HBSS、EBSS、PBS等都是与较弱的磷酸盐缓冲液相关的盐溶液。
常见的平衡盐溶液有Eargle液,Hanks’液、低钙镁和无钙、镁平衡盐溶液及磷酸盐缓冲液 (PBS)等。
D-Hanks平衡盐溶液是最常用的磷酸盐缓冲溶液之一,又称CMF-Hanks' Balanced Salt Solution、CMF-HBSS溶液或D-Hanks’ BSS, 主要由氯化钠、氯化钾、磷酸氢二钠、磷酸二氢钾、碳酸氢钠、葡萄糖等组成,不含钙离子和镁离子,pH值一般为7.2~7.4。
Leagene D-Hanks平衡盐溶液(1×,含酚红),不含钙离子和镁离子,含酚红,用重蒸超纯水配制,pH值7.4,经严格过滤除菌处理,内毒素含量低,可用于胰蛋白酶和EDTA 细胞消化液等各种无或低钙镁细胞培养用液的配制,组织和细胞的漂洗等。
主要成分:主要由 KCl、KH2PO4、NaCl、NaHCO3、Na2HPO4、葡萄糖等组成,含少量酚红。
操作步骤(仅供参考):1、无需配制,直接使用。
注意事项:1、在进行细胞培养过程中细胞的洗涤时,应注意无菌操作,避免被微生物污染。
北京雷根生物技术有限公司
PBS-BSA 溶液(含钙镁,1%BSA)
简介:
平衡盐溶液(Balanced Salt Solution ,BSS)与细胞生长状态下的pH 值、渗透压等环境状态一致,具有维持渗透压、控制酸碱平衡、供给细胞生存代谢所必需的能量和无机盐成分等作用,可满足体外实验中细胞生存并维持一定的代谢的基本需要。
PBS-BSA 溶液(含钙镁,1%BSA)主要由氯化钠、氯化钾、磷酸氢二钠、磷酸二氢钾组成,含Ca 2+、Mg 2+以及BSA ,pH 值为7.4,该试剂经过滤除菌,常用于细胞培养过程中细胞的洗涤或其他常规用途。
组成:
操作步骤(仅供参考):
1、 无需配制,直接使用。
1、 在进行细胞培养过程中细胞的洗涤时,应注意无菌操作,避免被微生物污染。
2、 为了您的安全和健康,请穿实验服并戴一次性手套操作。
编号 名称 R00092 Storage PBS-BSA 溶液(含钙镁,1%BSA) 500ml 4℃ 使用说明书 1份。
《深入了解earle's平衡盐质量标准》一、引言在生物学和生物化学领域,earle's平衡盐是一种经常被使用的培养基盐。
它是由美国生物学家默里·斯坦利·earle发明的,被广泛用于细胞培养、细胞生长等领域。
在这篇文章中,我们将深入探讨earle's平衡盐的质量标准,并从多个角度对其进行评估。
二、质量标准的定义和重要性质量标准是用于衡量一个产品或物质质量优劣的标准。
在生物科技领域中,对于培养基盐来说,质量标准尤为重要。
优质的earle's平衡盐应该具有清晰的化学成分及其比例,能够满足细胞培养的基本需求,同时不含有对细胞生长有害的杂质。
三、成分分析earle's平衡盐的成分非常丰富,包括多种无机盐和氨基酸。
其中,关键的成分包括氯化钠、氯化钾、磷酸盐、硫酸钙等。
这些成分对于细胞的正常生长和代谢起着至关重要的作用。
在评估一个批次的earle's 平衡盐时,我们需要对这些成分的含量进行严格的分析和检测,确保其符合质量标准要求。
四、杂质和纯度除了主要成分外,earle's平衡盐中可能会存在一些杂质,比如重金属离子、微生物污染等。
这些杂质会对细胞的生长和培养产生负面影响,因此在评估earle's平衡盐的质量时,需要对其杂质含量和纯度进行严格检测。
只有确保其纯度达到标准要求,才能够保证其在细胞培养中的良好表现。
五、个人观点和总结对于earle's平衡盐的质量标准,我个人认为需要从成分分析、杂质和纯度等多个方面进行综合评估。
只有确保每一批次的earle's平衡盐都符合严格的质量标准,才能够保证细胞培养的质量和结果的可靠性。
在生物科技领域中,对earle's平衡盐的质量标准要求十分严格和重要。
总结而言,earle's平衡盐的质量标准是生物科技领域中的一个关键问题,对其进行全面评估和严格把关,能够确保细胞培养实验的可靠性和稳定性。
碧云天生物技术/Beyotime Biotechnology订货热线: 400-1683301或800-8283301订货e-mail:******************技术咨询: *****************网址: 碧云天网站 微信公众号Earle's Balanced Salt Solution (with Ca2+ & Mg2+, 自噬诱导试剂)产品编号产品名称包装C0214-500ml Earle's Balanced Salt Solution (with Ca2+ & Mg2+, 自噬诱导试剂)500ml产品简介:碧云天生产的Earle's Balanced Salt Solution (with Ca2+ & Mg2+, 自噬诱导试剂),简称EBSS with Ca2+ & Mg2+,含117.24mM NaCl, 5.33mM KCl, 26.19mM NaHCO3, 1.01mM NaH2PO4, 1.80mM CaCl2, 0.813mM MgSO4, 5.56mM D-Glucose。
本Earle's Balanced Salt Solution溶液经过过滤除菌,可以直接用于细胞培养过程中细胞的洗涤、溶液的配制、细胞计数时的稀释等常规用途。
使用前不必再进行稀释或过滤除菌等任何处理。
本产品简称EBSS,常用于诱导细胞自噬。
诱导细胞自噬时,吸净细胞培养液,用EBSS洗涤1-3次,然后在EBSS中孵育例如10、20、40或60min就可以诱导细胞发生非常显著的自噬。
多次充分洗涤细胞,可以确保发生非常显著的自噬。
不同细胞诱导发生自噬所需的时间有所不同,初次实验需要适当摸索一下诱导自噬的时间。
推荐使用碧云天生产的C3012 AdPlus-mCherry-GFP-LC3B、C3011 Ad-mCherry-GFP-LC3B、AF5225 LC3B Rabbit Polyclonal Antibody (KO Validated)或AL221 LC3B抗体(兔多抗)检测细胞自噬。
北京雷根生物技术有限公司
磷酸缓冲盐溶液(1×PBS,含钙镁)
简介:
HBSS 、EBSS 、PBS 等都是与较弱的磷酸盐缓冲液相关的盐溶液。
常见的平衡盐溶液有Eargle 's 液、Hank's 液、磷酸盐缓冲溶液(PBS)等。
Leagene 磷酸缓冲盐溶液(1×PBS,含钙镁)即Phosphate-Buffered Saline ,是最常用的磷酸盐缓冲溶液之一,又称Dulbecco 's 磷酸缓冲盐溶液、Dulbecco 's PBS 、D-PBSB, 主要由氯化钠、氯化钾、磷酸氢二钠、磷酸二氢钾组成,含少量Ca 2+、Mg 2+,pH 值为7.4,该试剂经过高压灭菌,常用于细胞培养过程中细胞的洗涤或其他常规用途,该试剂为1×工作液,直接使用。
组成:
操作步骤(仅供参考):
1、 无需配制,直接使用。
注意事项:
1、 在进行细胞培养过程中细胞的洗涤时,应注意无菌操作,避免被微生物污染。
2、 Leagene 磷酸缓冲盐溶液(1×PBS,含钙镁)由于含有钙离子,易产生少许沉淀,出现该
种情况后,一般置于温浴至沉淀溶解即可,如果产生较多沉淀应弃用。
3、 该试剂经高压灭菌处理。
编号 名称 CC0004 Storage 磷酸缓冲盐溶液(1×PBS,含钙镁) 500ml 4℃ 使用说明书 1份。
北京雷根生物技术有限公司 Earle's 平衡盐溶液(10×EBSS,含钙镁糖)简介:Earle's 平衡盐溶液是最常用的磷酸盐缓冲溶液之一,又称Earle 's Balanced Salt Solution 、Earle's BSS 、EBSS, 主要由氯化钠、氯化钾、磷酸氢二钠、碳酸氢钠等组成,有时亦含钙镁、葡萄糖、酚红,pH 值一般为7.2~7.4。
Earle's 平衡盐溶液(10×EBSS,含钙镁糖),含Ca 2+、Mg 2+、葡萄糖,不含酚红,用去离子水或双蒸水配制,pH 值7.4,经严格过滤除菌处理,内毒素含量低,可用于胰蛋白酶-EDTA 细胞消化液等各种无或低钙镁细胞培养用液的配制以及组织和细胞的漂洗等。
组成:操作步骤(仅供参考):1、 进行细胞培养过程中细胞的洗涤时,按10×EBSS 溶液:无菌水=1:9进行稀释,即取10×EBSS 溶液1份、无菌水9份,充分混匀,即获得EBSS 工作液。
2、 进行常规实验(不要求无菌)时,按10×EBSS 溶液:双蒸水或去离子水=1:9进行稀释,即取10×EBSS 溶液1份、双蒸水或去离子水9份,充分混匀,即获得EBSS 工作液。
注意事项:1、 在进行细胞培养过程中细胞的洗涤时,应注意无菌操作,避免被微生物污染。
2、 Leagene Earle 's 平衡盐溶液(10×EBSS,含钙镁糖)由于含有钙离子,易产生少许沉淀,出现该种情况后,一般置于温浴至沉淀溶解即可, 如果产生较多沉淀应弃用。
3、 该试剂经过滤除菌。
编号 名称 CC0046 Storage Earle's 平衡盐溶液(10×EBSS,含钙镁糖) 500ml 4℃ 使用说明书 1份。
北京吉美生物技术有限公司
Earle's平衡盐溶液(10×EBSS,含钙镁糖)
产品简介:
平衡盐溶液(Balanced Salt Solution,BSS)与细胞生长状态下的pH值、渗透压等环境状态一致,具有维持渗透压、控制酸碱平衡、供给细胞生存代谢所必需的能量和无机盐成分等作用,可满足体外实验中细胞生存并维持一定的代谢的基本需要。
BBS配方常有改动,如Hank,s BBS有不含钙镁或酚红的,也有含钙镁含酚红的等等,Dulbecco,s PBS有不含钙镁或含钙镁的等。
Eargle,s平衡盐溶液是最常用的磷酸盐缓冲溶液之一,又称Eargle,s Balanced Salt Solution、Eargle,s BSS、EBSS,主要由氯化钠、氯化钾、磷酸氢二钠、碳酸氢钠等组成,有时亦含钙镁、葡萄糖、酚红,pH值一般为7.2~7.4。
Jimei Earle's平衡盐溶液(10×EBSS,含钙镁糖),含Ca2+、Mg2+,葡萄糖,不含酚红,用去离子水或双蒸水配制,pH值7.4,经严格过滤除菌处理,内毒素含量低,可用于胰蛋白酶-EDTA细胞消化液等各种无或低钙镁细胞培养用液的配制以及组织和细胞的漂洗等。
尤其适用于神经细胞。
该试剂为10×浓缩液,使用之前应稀释至1×。
产品组成:
操作步骤(仅供参考):
1、进行细胞培养过程中细胞的洗涤时,按10×EBSS溶液:无菌水=1:9进行稀释,
即取10×EBSS溶液1份、无菌水9份,充分混匀,即获得EBSS工作液。
2、进行常规实验(不要求无菌)时,按10×EBSS溶液:双蒸水或去离子水=1:9进
行稀释,即取10×EBSS溶液1份、双蒸水或去离子水9份,充分混匀,即获得EBSS
工作液。
注意事项:
1、在进行细胞培养过程中细胞的洗涤时,应注意无菌操作,避免被微生物污染。
2、Jimei Earle's平衡盐溶液(10×EBSS,含钙镁糖)由于含有钙离子,易产生少许沉淀,出
现少许沉淀情况后,一般置于温浴至沉淀溶解即可,如果产生较多沉淀应弃用。
3、该试剂经过滤除菌。
有效期:6个月有效。